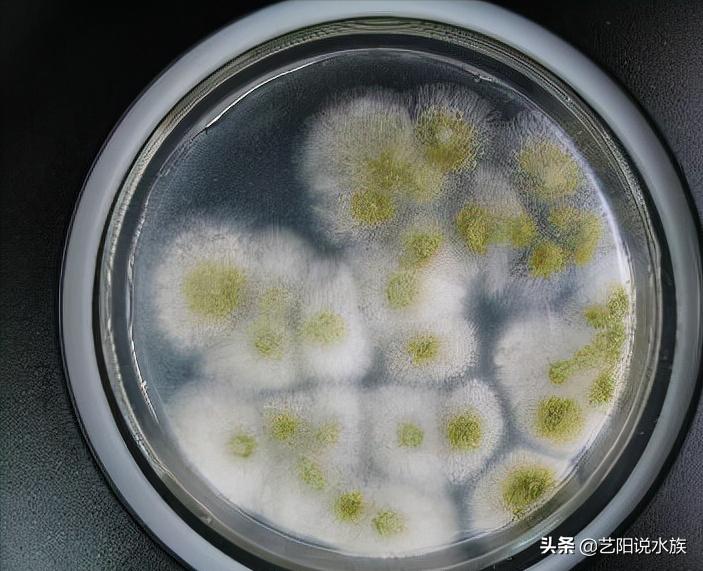
观赏鱼水霉病死鱼后鱼池怎么处理,观赏鱼水霉病怎么治疗最快最有效

大家好,我是爱养鱼的艺阳,【关注】我和你一起分享养鱼的快乐。 有时候突然间你会发现你的观赏鱼怎么“长毛”了,很多的灰白棉絮状物,这个时候,你的观赏鱼可能是得了水霉病了,这种病一般情况下是不致命,但是使用不恰当的处理和治疗,持续严重感染还是会导致观赏鱼死亡的。

打开百度APP看高清图片
水霉病
咱们先来说说什么是水霉吧
来了解一下水霉对治疗会有很好的启发的。水霉病的引起是由于水霉菌感染所引起,水霉菌广泛存在于各种淡水或者咸水领域以及土壤中,在死亡的有机物上腐生,他们适应的温度是10-15℃,此时最适宜生长以及繁殖!但是当温度高于25℃的时候,水霉就会减弱生长能力及繁殖能力,这个温度是不容感染的,但是一般热带观赏鱼的水温会控制再25℃以上,还是会感染是怎么回事呢?答案就是鱼体受损。抵抗力下降造成的。水霉就像是棉花一样,由一根一根的菌丝组成,不知道大家有没有见过食物发霉,菌丝一半在体外,一半在体表内,靠这样摄取鱼身体上的营养存活。
造成观赏鱼水霉病的原因也是有很多是,水质差、温度不合适、有机物过多、观赏鱼受伤、草缸缺少二氧化碳都是可以导致观赏鱼引起水霉的。箭头就简单讲一下这几种。
1.受伤导致当鱼儿紧张或者拥挤,打架等造成体表受伤后,造成体表受伤或坏死,这时水中的水霉孢子就可以附着在坏死的组织上开始生长繁殖,这时我们可以用消毒剂给鱼儿受伤的部位进行涂抹来杀菌,然后升温至28-33℃之间,具体看您养的什么鱼。不同于的适应温度也是不同的。升温的目的是加快鱼儿的新陈代谢,提升抵抗力 2.水质差,其实大多数鱼病都是水质差导致,因为水质差会导致鱼儿抵抗力下降,抑制不住有害菌,从而导致水霉菌侵入。所以我们养鱼最起码要保证水质。 3.有机物过多,和上面的水质差大径相同,水霉菌是附着在腐败的植物或者有机物上的,有机物过多会导致水质差,水质差又会导致鱼儿的抵抗力下降。水中的水霉菌就会附着在水体。 4.草缸内如果二氧化碳少,那么植物就会不健康,腐烂,而水霉菌就是喜欢腐烂的动植物,也会造成水霉菌的泛滥。 5.温度不合适,换水的时候没有进行困水,温度较低,造成鱼儿产生应激反应,这时的鱼儿抵抗力也是比较低的,由于也是温度较低,非常合适水霉的生长,从而产生水霉的爆发。

其实艺阳个人认为,水霉是一直存在于水中的,我们饲主保证水质、温度。的情况下,鱼儿身体好的情况下鱼儿体表的黏膜就可以有效的防御很大一部分的有害菌,但是鱼儿一旦虚弱、受伤、抵抗力下降,哪些有害菌,有害霉就会趁机而入。
关于治疗水霉,艺阳的方法就是“升温、下盐、黄粉”然后静等几天就差不多了。其实很简单,只要弄清楚病因,治疗起来很方便的。还有就是去水族馆买专用的药物,来控制霉菌,然后升温,注意下药的时候不能换水,严格按照药剂说明进行操作,不然没有作用的。 好了,上面就是我个人的一些体会,希望可以帮助到新手鱼友,有什么不正确地希望鱼友们指正,我是艺阳,【关注】我和你一起分享养鱼的快乐。
